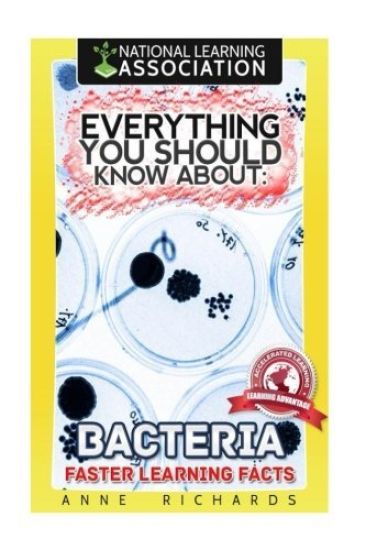
Everything You Should Know About Bacteria

Profils de résistance aux antibiotiques des bactéries entériques chez le poulet
Anne Mutsami; Paul Okemo; Richard Cheruiyot
Editions Notre Savoir
2023
pokkari
Ce livre traite de la r sistance aux antibiotiques des Escherichia coli isol s chez les poulets de chair et les poulets indig nes dans diff rentes fermes du comt de Kericho. Les Escherichia coli ont t isol s partir d' couvillons rectaux de poulets d' ges diff rents. L'isolement et l'identification des bact ries ont t effectu s, suivis d'un antibiogramme. Les isolats r sistants ont fait l'objet d'une extraction d'ADN plasmidique et d'une analyse sur gel d'agarose en vue d'une s paration des bandes et d'une analyse bas e sur leur poids mol culaire.